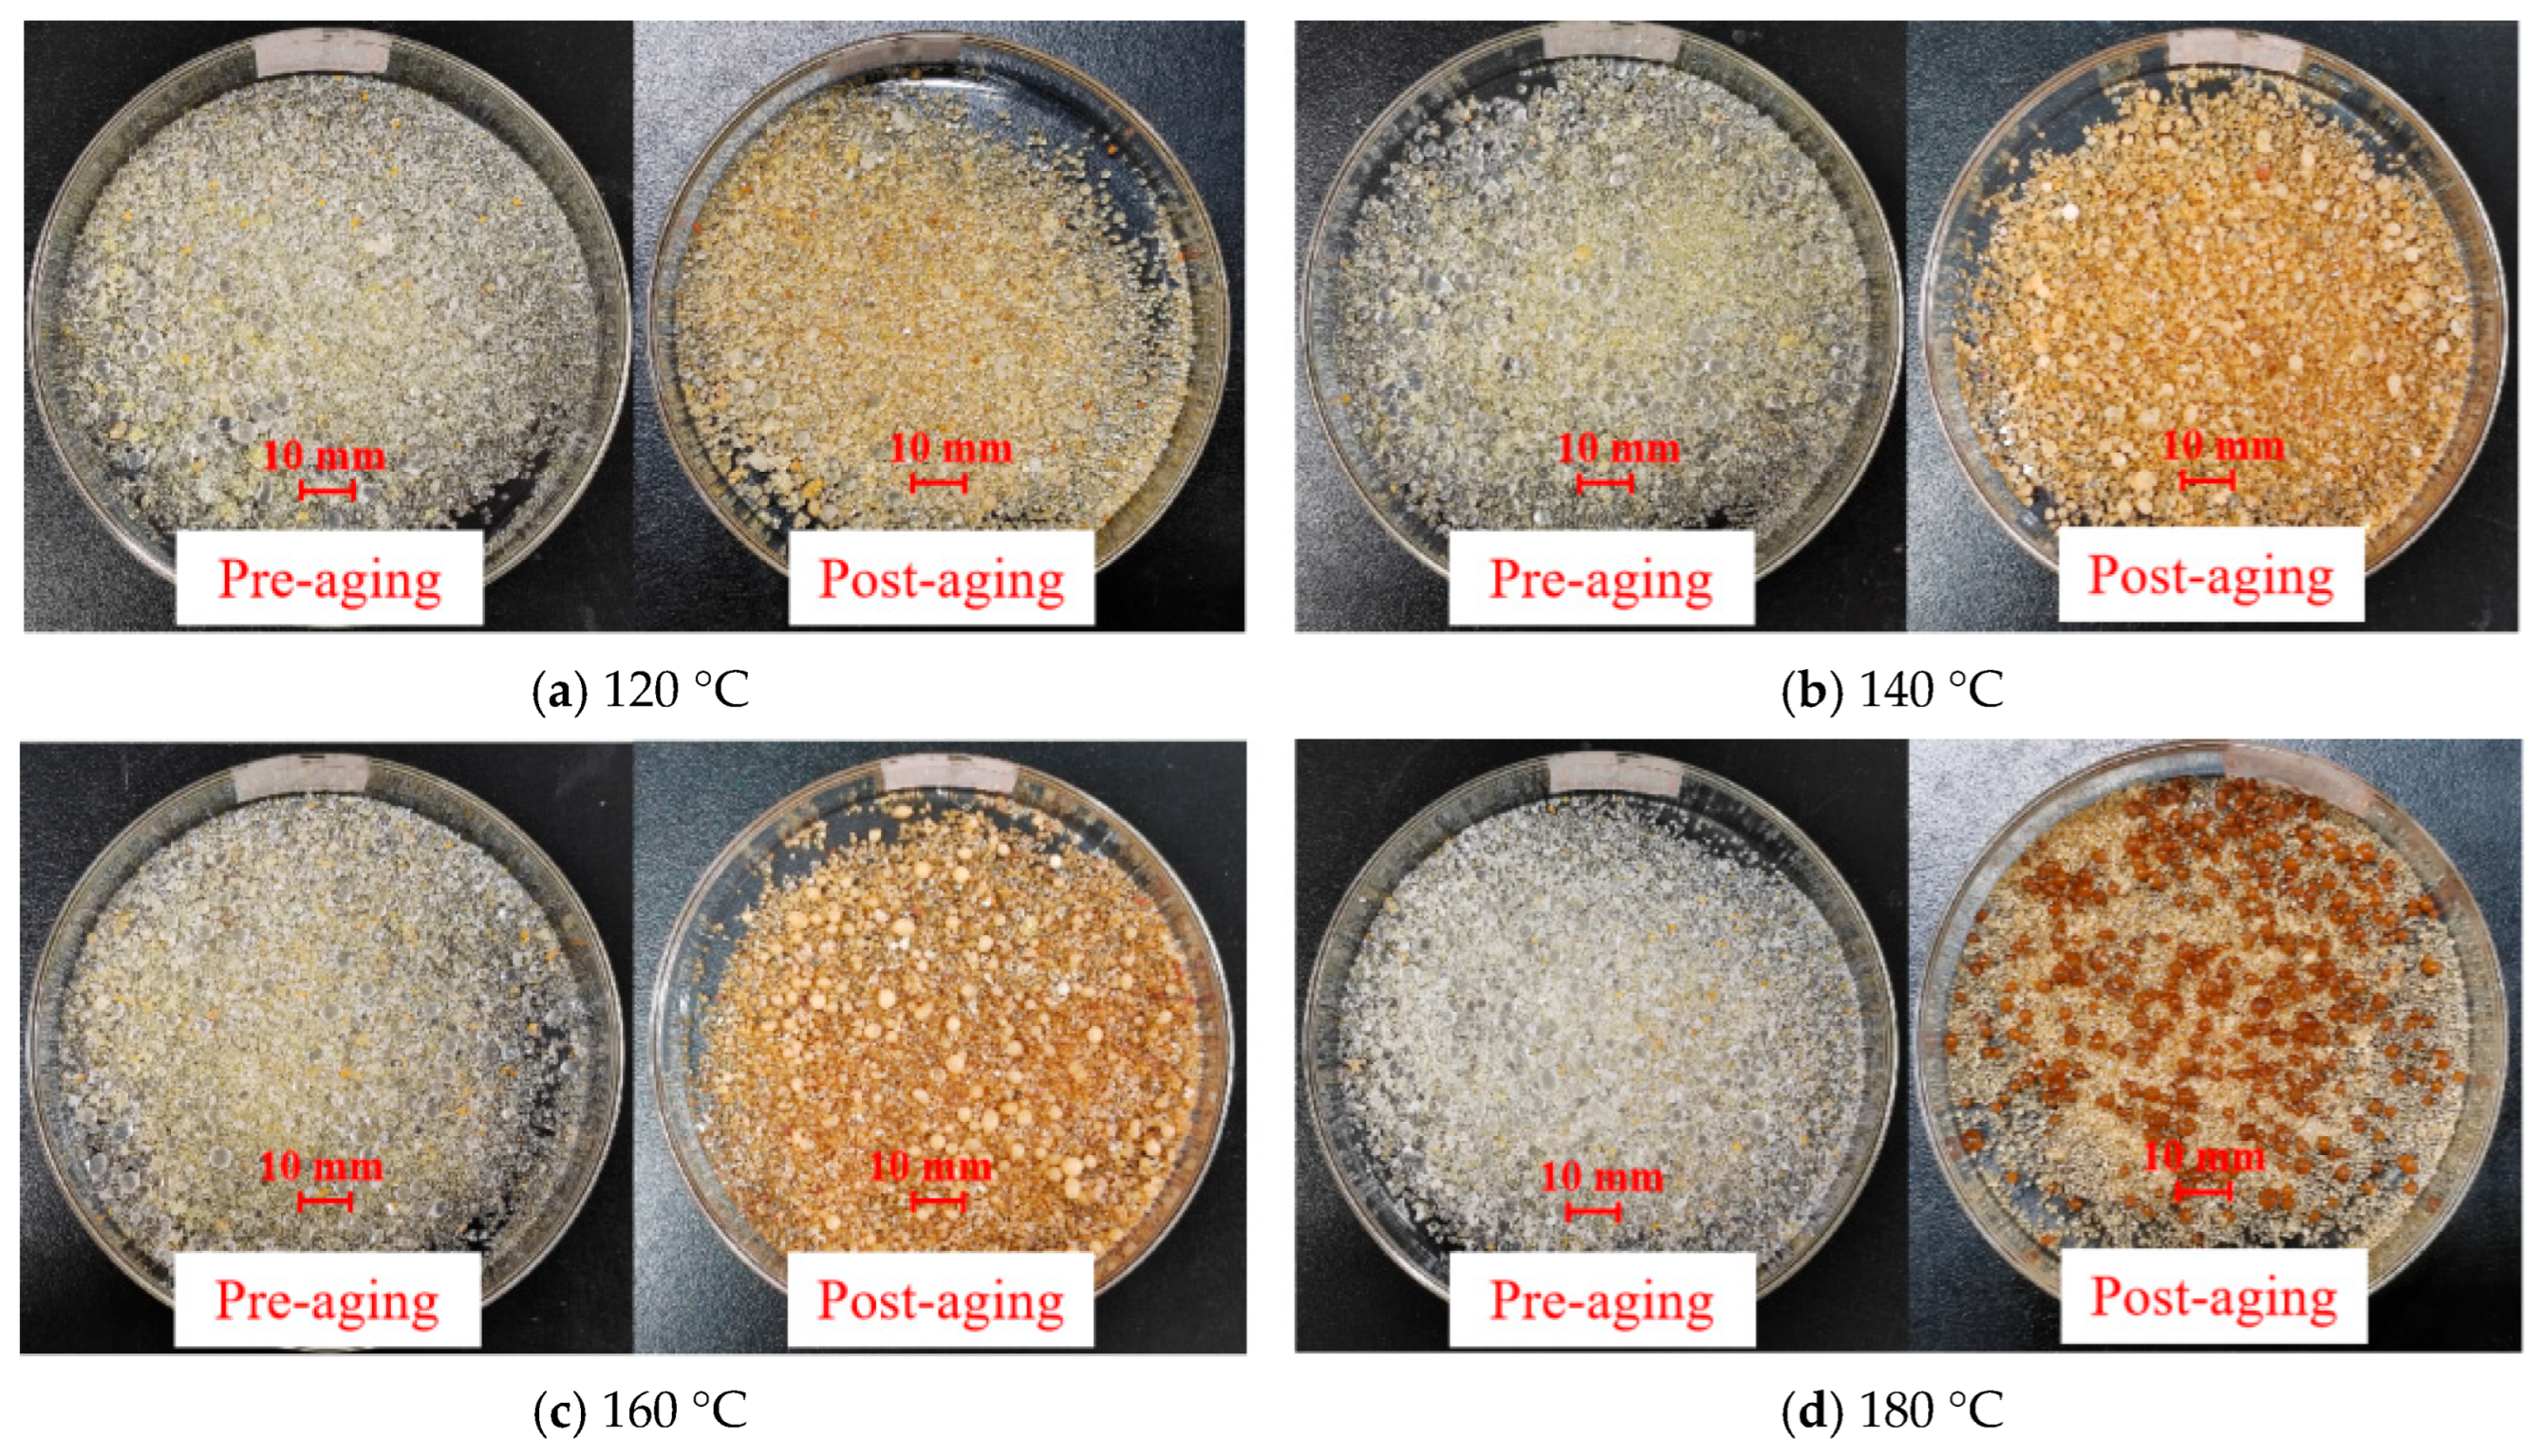
Nanomaterials 15 01715 g019

1. Introduction
Lost circulation is the phenomenon in which a large amount of drilling fluids loss into the formation during drilling [
1,
2]. Drilling fluid loss IS one of the major challenges faced in current drilling operation and an important factor restricting safe drilling. Lost circulation will consume a lot of drilling fluid and prolong the drilling time [
3]. During drilling, a large amount of drilling fluid is lost into the formation. If not properly addressed, it can lead to well collapse, blowouts, pipe sticking, and even borehole abandonment, resulting in major engineering accidents [
4,
5,
6]. Lost circulation seriously restricts the drilling speed, increases the non-production time, and causes significant economic losses [
7]. According to statistics, the occurrence rate of lost circulation accounts for about 20–25% of the total number of drilling wells in the world, and the annual cost of plugging is as high as 40 × 10
8 USD [
8]. With the expansion of oil and gas exploration and development to deep–ultra-deep and unconventional oil and gas fields, drilling engineering is facing many limitations and technical bottlenecks. Fractured formation leakage is one of the complex drilling accidents that are difficult to control [
9,
10,
11], and it is also a bottleneck technical problem that restricts the efficient drilling of shale gas [
12], which seriously affects the progress of drilling engineering and brings great risks and challenges to drilling operations [
13,
14].
The plugging material is the key to leakage prevention and plugging [
15]. The conventional plugging materials are mainly composed of rigid particles, elastic particles, and fibers [
16]. When the conventional bridging plugging materials are used to deal with complex leakage, there are still limitations: it is difficult to grasp the matching between the particle size of the plugging material and the formation fracture, and the pressure bearing capacity of the plugging slurry is insufficient [
17], so the success rate of one-time plugging is low [
18,
19]. After the completion of plugging with cement slurry and chemical consolidation materials, it is necessary to drill and plug again to increase the non-production operation time. Although the gel plugging material has good self-adaptability and matches well with the fracture size [
20], it still has low strength and insufficient temperature resistance.
The traditional idea of bridging plugging material is to add the bridging plugging material to the drilling fluid on the ground and then pump it into the lost circulation zone. In this paper, the idea is to inject the liquid phase plugging emulsion, which is easily enters the unknown fractures with different openings and generates bridging particles with different particle sizes in the fractures, while the particles in the wellbore can be pumped out without drilling plugs. In recent years, in the field of oil and gas, scholars at home and abroad have carried out research on high-molecular polymer material [
21,
22], supramolecular assembly systems, self-assembly material [
23], phase transition fracturing systems, self-growing gel plugging emulsion, in situ autogenetic particle profile control systems, self-consolidation resin plugging emulsion, and phase-change materials [
24]. Kuroiwa et al. [
25] discovered a class of thermochromic small-molecule organogold compounds, which are different from conventional small-molecule organogels. The gels are formed by introducing an ether bond into the alkyl chain of a divalent cobalt complex of 4-alkyl-1,2,4-triazole, and then changing from a light pink solution to a blue gel phase under chloroform heating conditions. The thermochromic transition is completely reversible. Therefore, it is widely used in the design of thermal response and self-assembled molecular wires. Saudi Aramco mixes resin, curing agent, surfactant, and water to form an O/W emulsion fracturing system [
26,
27], which is initially a uniform emulsion at 66 °C, facilitating the formation of proppant particles in deep formations. Wang [
28] optimized the formula of epoxy resin emulsion and curing agent and prepared the phase transition fracturing fluid system. Additionally, nanomaterials can enhance the mechanical properties of materials [
29]. Guadagno et al. [
30] proposed the design of toughened self-healing supramolecular resins that achieve conductive carbon nanotubes at the electrical percolation threshold (EPT) with minimal nanofiller content. These nanotubes are dispersed within a self-healing polymer matrix to counterbalance the insulating properties of epoxy resin matrices. Zhao and Du proposed self-supporting phase transition fracturing technology based on supramolecular gel [
31,
32,
33,
34]. Based on the bionic concept of mussel, Dai et al. [
35] developed a self-growing hydrogel particle system, which increases the median particle size of self-growth by 10 to 15 times, and is easy to inject and migrate far. Wang et al. [
36] disclosed a deep profile control system for in situ generation of particles, which does not contain a solid phase before mixing, and can generate particles according to the fracture scale to achieve matching fracture plugging. Huang et al. [
37] utilized in situ methane desorption and oxygen co-combustion to generate high-temperature, high-pressure gas shock waves. The resulting in situ shale debris particles act as self-supporting proppants, enhancing fracture conductivity under reservoir stress. These self-supporting particles exhibit mechanical properties that closely match the shale matrix, offering the natural advantage of reducing reliance on artificial proppants and simplifying operational procedures. Du et al. [
38] used organic resin as raw material to prepare a temperature-sensitive self-curing resin material, which was further compounded with high-temperature-resistant fiber and other materials to construct a bridging blocking–thermally induced consolidation high-temperature plugging emulsion. The strength of the system can reach more than 6 MPa at the temperature of 90–190 °C.
Mo et al. [
39] developed a novel epoxy resin self-degrading sealing agent by incorporating amine-modified additives and optimized catalysts within an epoxy–acid anhydride system. This innovative material demonstrates stable performance at 250 °C temperatures while maintaining excellent dynamic thermomechanical properties below 140 °C, proving its superior thermal resistance. At 30 MPa, the compressive crushing rate is less than 10% and the elastic deformation rate is 36.8%. Gong et al. [
40] developed a microencapsulated polymer with sustained-release and viscosity-enhancing properties through reverse-phase emulsion polymerization and in situ polymerization methods. The polymer features a polyurethane prepolymer shell and a polymer core. When prepared under conditions of 800 rpm mixing speed, 50 °C reaction temperature, 4 h reaction time, and a 1:4 shell-to-core ratio, the resulting microcapsule polymer exhibits a smooth, intact shell surface with high sphericity. Zhang et al. [
41] developed a novel temperature-sensitive non-reversible material (TS-LCM) particle composed of diglycidyl ether of bisphenol A (DGEBA)) and 4,4′-diaminobiphenyl, which belongs to a class of thermoresponsive shape memory polymers. TS-LCM exhibits a glass transition temperature of 70.24 °C, maintains over 99% shape fixation ratio at room temperature, and achieves 100% shape recovery above the glass transition temperature (Tg). Activated TS-LCM particles demonstrate exceptional compressive strength.
Researchers at home and abroad have carried out research on liquid–solid phase transition fracturing fluid systems, in situ self-generating particle profile control and water plugging emulsions, self-growing gel plugging emulsions, and self-consolidating resin plugging emulsions, but there is no report on self-adaptive in situ plugging technology. The drilling plugging process is different from the fracturing propping process. The proppant needs to maintain the oil and gas seepage channel in the fracture, and the proppant is required to have uniform particle size distribution and high sphericity, while the plugging process requires the plugging agent to have wide particle size distribution and excellent mechanical properties, so as to form a dense pressure-bearing plugging layer in the fracture. The self-growing hydrogel particle system can accumulate and self-grow in the reservoir. The system is easy to inject and migrate far, but the particle size distribution is uniform, the particle size is small, and there is little research on its compressive strength. Resin plugging agents are also a hot research topic at present. Aiming at the technical problem of drilling plugging in high-temperature, broken, and collapsed formations, combined with the concept of physical bridging and chemical consolidation, the self-consolidating resin plugging emulsion has a wide range of curing temperatures, but the compressive strength of the consolidated body needs to be improved, and how to discharge the formation after the formation of the consolidated body is also under-researched. Microcapsule globular polymer has a smooth shell, high degree of embedding, uniform particle size, and little description of its compressive strength. The sealing material also needs materials of different particle sizes to block the leakage. The design process of microcapsule material is complicated, and the controllable range of the particle size of sealing material is limited. In addition, the self-degrading plugging agent prepared with epoxy resin as raw material also has the limitation of particle size and is highly dependent on the scale of injected formation fractures.
Therefore, in order to solve the problem of fracture leakage in high-temperature formations and improve the one-time plugging rate, a new temperature-activated liquid–solid phase transition plugging emulsion was developed based on the principle of thermosetting resin emulsification and high-temperature crosslinking polymerization. The lost circulation system is liquid before being injected into the stratum. The lost circulation system enters into the stratum fractures with different openings and is stimulated by high temperatures. The particle strength is continuously increased during the reaction, and finally, high-strength lost circulation particles with a wide particle size distribution are generated in situ in the fractures. These particles seal the fractures in a self-adaptive matching manner and form a compact pressure-bearing sealing layer, which effectively seals the high-temperature stratum fractures and improves the success rate of plugging.